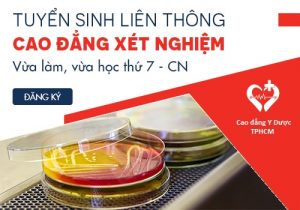

Lưu trữ danh mục: LIÊN THÔNG CAO ĐẲNG XÉT NGHIỆM
Thông tin tuyển sinh liên thông Cao đẳng Xét nghiệm TP HCM năm 2021
Thông tư chuẩn hóa cán bộ Y tế sắp có hiệu lực dẫn đến việc...
Điều kiện học Liên thông Cao Đẳng Xét Nghiệm TPHCM năm 2021 là gì?
Thí sinh có nguyện vọng đăng ký theo học Liên thông Cao Đẳng Xét Nghiệm...
Tuyển sinh Liên thông Cao đẳng Xét nghiệm TPHCM năm 2021 không cần thi tuyển đầu vào
Trường Cao đẳng Y Dược Pasteur thông báo tuyển sinh Liên thông Cao đẳng Xét...
Những lưu ý khi tham gia liên thông Cao đẳng Xét nghiệm TPHCM
Thí sinh mong muốn liên thông Cao đẳng Xét nghiệm TPHCM năm 2018 nên lưu...
Học liên thông Cao đẳng Xét nghiệm TPHCM trong mấy năm?
Với thời gian đào tạo linh hoạt và rút ngắn liên thông cao đẳng Xét...